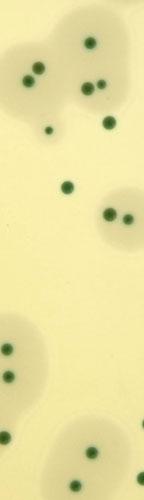

Estudo da Escola Superior de Biotecnologia testa bactéria anti-Listeria
A Escola Superior de Biotecnologia (ESB) encontra-se a testar uma bactéria com propriedades anti-listeria. Recorde-se que a listeriose é uma infecção de origem alimentar e que afecta principalmente indivíduos com o sistema imunitário debilitado, idosos e grávidas. Neste último caso, pode mesmo originar aborto ou parto prematuro.
Especialista no âmbito da Microbiologia, Prof.ª. Doutora Paula Teixeira da ESB produziu dois grupos de alheiras: umas inoculadas com listeria e outras com listeria juntamente com a bactéria do ácido láctico (a anti-listeria). Enquanto que nas primeiras a listeria aumentou, nas segundas foi destruída. Refira-se que as alheiras produzidas industrialmente com adição e sem a adição da bactéria anti-listeria foram comparadas por um painel de provadores. Não foram detectadas diferenças significativas ao nível do sabor e aroma entre os dois produtos.
A bactéria isolada demonstra possuir atributos para ser usada como cultura bio-protetora na produção de alheira, sendo uma alternativa para melhorar a segurança destes alimentos. Trata-se de uma bactéria que não possui qualquer factor de virulência, pelo que pode ser adicionada durante o processo de produção de alheiras. A utilização desta bactéria na produção de outros enchidos tradicionais portugueses está atualmente a ser avaliada.
88 por cento das grávidas não sabe o que é a listeriose
Os dados obtidos demonstram uma evidente falta de conhecimentos sobre hábitos de segurança alimentar a ter durante a gravidez e sobre a infecção causada por listeria. Das 956 inquiridas, 88 por cento revelou nunca ter ouvido falar em listeriose e, das 12 por cento que afirmaram conhecer a infecção, quase todas (94 por cento) não sabe quais os problemas que a infecção pode causar. Revela, também, que é premente informar os profissionais de saúde, uma vez que, de 749 inquiridos, 69 por cento considerou que a listeriose não foi bem abordada durante a sua formação académica. Dentro deste grupo, a esmagadora maioria (87,9%) admitiu ser de grande utilidade a disseminação de mais conhecimentos sobre esta temática.
Com base nestas conclusões foi estruturado o primeiro projeto de educação e informação sobre prevenção de listeriose, uma doença que não é ainda de declaração obrigatória. Neste âmbito, foi criado um website (www.esb.ucp.pt/listeriose) e foram produzidos 112 mil folhetos de divulgação, 2.400 posters, 20 mil marcadores de livros e seis mil dossiês de informação para profissionais de saúde. Alguns destes materiais de informação podem ser solicitados através do website indicado.
Para saber mais sobre listeriose pode ler este artigo de revisão.





